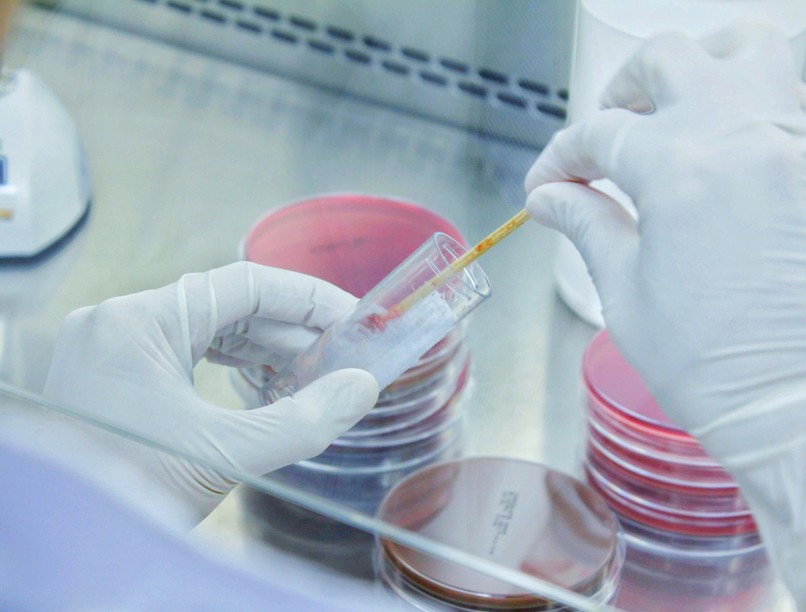
köptető, gyerek, halál, fagyálló

A WHO újabb vizsgálatokat rendelt el az ügyben.
Újabb vizsgálatokat rendelt el az Egészségügyi Világszervezet (WHO) azoknak a recept nélkül kapható köptetőszirupoknak az ügyében, amelyek ipari oldószer és fagyállószer származékokat tartalmaztak és több mint 300 gyerek halálát okozták október óta három országban is - jelentette a Reuters hírügynökség.
Az első megbetegedést 2022 júliusában Gambiában regisztrálták, de halálos eseteket jelentettek később Üzbegisztánból és Indonéziából is. A szervezet hétfőn jelentette be, hogy kiterjeszti a vizsgálatokat a Kambodzsában, Kelet-Timoron, a Fülöp-szigeteken, és Szenegálban kapható köptetőkre is a gyártás során köptetőbe került kis mennyiségben is halált okozó toxikus anyagok - dietilén-glikol és etilén-glikol - okozott vesekárosodást, és több gyerek is belehalt a mérgezésbe.
A WHO októbertől kezdve négy indonéz és két indiai gyógyszergyár köptetőszirupjainak összetételét vizsgálta, ezzel egyidőben pedig ellenőrzés alá vonta a gyártók beszállítóit is a hatékonyabb kivizsgálás érdekében. Az érintett gyógyszergyártók ugyan tagadták, hogy az egészségre ártalmas anyagokat használtak volna a köptetők elkészítésekor, de a szakértők a decemberben lezárult első körös vizsgálatok után az egyik indiai gyógyszergyár termékében ipari oldószer és fagyállószer nyomaira bukkantak.
Az újabb halálesetek megelőzése érdekében a WHO a termékek használatának felfüggesztését rendelte el és a Reuters értesülése szerint a szervezet fontolóra vette a köptetőszirupok forgalomból való kivonását is azok egészségügyi kockázata miatt.
A WHO felszólította a gyógyszergyártókat arra is, hogy ellenőrizzék termékeik összetételét. Az egyik indonéziai gyógyszergyár ügyvédje - Hermansyah Hutagalung - úgy nyilatkozott: "a beszállítókra kell lecsapni, ők az igazi bűnözők" mert a gyógyszergyárakat kijátszva meghamisítják az alapanyagok hivatalos dokumentumait".
A WHO iránymutatásokat határoz meg a gyógyszergyártási szabványokról világszerte, és támogatja az esetleges hiányosságok kivizsgálását, de nincs jogi felhatalmazása vagy végrehajtási jogköre arra, hogy közvetlen intézkedéseket hozzon a szabálysértőkkel szemben.
Olvasta már?
- Ezzel a gyógynövénnyel nagyon vigyázzon, ha szívbeteg vagy gyógyszert szed!
- Rendszeresen használ orspray-t? Jobban teszi, ha módjával alkalmazza!
- Orrdugulás utáni fülfájás: így gyógyíthatjuk otthon a fül-orr-gégész szerint
Rákkeltő vegyület van benne: több cukorbetegség elleni gyógyszer is érintett
Kövesse az Egészségkalauz cikkeit a Google Hírek-ben, a Facebook-on, az Instagramon vagy a X-en,Tiktok-on is!